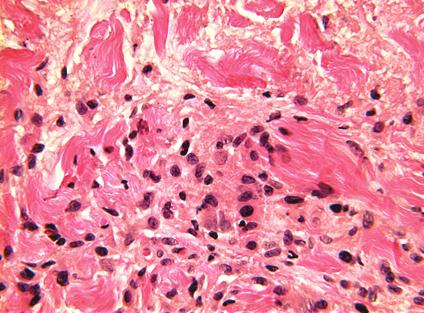

医声医识 | 皮肤科医生的相面术
一
病史汇报
01
基本信息:
男,59岁,因“躯干、四肢皮疹1年半,加重半年”入院。
02
现病史:
2022.07患者无明显诱因双上肢、左侧足踝部出现散在绿豆至黄豆大小皮疹,高出皮面,色红,予口服中药汤剂及外用药膏治疗1周,部分皮损消退。2023年1月至12月多家医院就诊,先后诊断湿疹,麻风,泛发性发疹性组织细胞瘤,栅栏状肉芽肿伴嗜中性肉芽肿性皮炎。完善血常规、肝肾功能电解质、自身免疫抗体、TPPA等检查未见明显异常。皮肤活检检查:表皮大致正常,真皮浅层见组织细胞及多核巨细胞形成的栅栏状肉芽肿,部分中央可见纤维素样坏死,周围淋巴细胞浸润,肉芽肿内见中性粒细胞浸润,肉芽肿周围见黏液沉积。S100、CD1a:阴性;CD68:阳性;抗酸染色:阴性。病理诊断考虑“肉芽肿性炎症”。予依巴斯汀10mg qd抗组胺,辅以卤米松乳膏、10%尿素软膏外用,配合红光、亚红斑量紫外线照射治疗、中药熏蒸等综合治疗未见明显好转,仍逐渐发展至全身。病程中患者皮疹反复未愈,无皮肤瘙痒,无关节肿痛,无口腔溃疡,无畏寒、发热,否认有类似皮损家族史。患病以来患者精神好,胃纳可,睡眠好,大小便正常,无体重明显下降。
03
体格检查:
一般检查:神清,查体配合,生命体征平稳,余未见异常。
专科检查:全身泛发性红斑块、丘疹,边缘隆起,部分融合。



图:患者全身泛发肤色、红色丘疹,部分融合成斑块,边缘隆起呈环状。
04
辅助检查:
1)实验室检查:
常血常规:淋巴细胞%:14.3%↓,单核细胞%:11.7%↑,嗜伊红细胞:44×10^6/L↓,淋巴细胞绝对值:0.62x10^9/L↓,中性淋巴比值:5.0↑,血小板淋巴比值:333.9↑。
糖化血红蛋白:5.3%,血糖:4.6mmol/L。
血脂检测:低密度脂蛋白胆固醇:4.27mmol/L↑,胆固醇:5.62mmol/L,脂蛋白(a):509mg/L↑,游离脂肪酸:0.59mmol/L↑,甘油三酯:1.09mmol/L,非高密度脂蛋白胆固醇:4.38mmol/L↑,载脂蛋白E:51.0mg/L↑。
血沉:26mm/h↑,全血C反应蛋白:6.43mg/L↑。
外周血涂片:嗜中性粒细胞:72.0%,嗜酸粒细胞:2%,淋巴细胞:16.0%↓,单核细胞:10.0%↑。
T.B.NK(2024-03-20):CD3+ Total T:85.31%↑,CD4+ T cell:45.22%,CD8+ T cell:38.10%,CD4+/CD8+:1.19,CD19+Total B:6.09%,Total NK:8.40%,T+B+NK:99.80%。
抗核抗体:阳性(+),核型:颗粒型。
骨髓涂片:骨髓象增生减低,以红系、巨核系为著。粒系比例相对增多,部分伴退行性变。NAP积分增高。片上成熟单核细胞较易见,可见少量异形淋巴细胞。
人免疫缺陷病毒抗体(Anti-HIV):(酶标)阴性。
肿瘤指标:神经元特异性烯醇酶:20.30ng/ml↑,甲胎蛋白:7.67ng/mL↑, 鳞癌相关抗原:5.6ng/mL↑,游离甲状腺素:11.50pmol/L↓。
2)影像学检查:
胸部CT扫描:两肺微小结节,建议12个月随诊,附见肝右叶低密度影。
B超:肝囊肿。胆囊、胰腺、脾脏、双肾、膀胱未见明显异常。双侧输尿管未见明显扩张。甲状腺左叶结节,TI-RADS2类。双侧甲状旁腺未显示。双侧颈部、双侧锁骨上、双侧腋下、双侧腹股沟未见明显异常肿大淋巴结。双下肢动脉内中膜少量斑点,血流通畅。双下肢深静脉未见明显血栓。
心脏超声:静息状态下经胸超声心动图未见明显异常功能诊断:左心收缩功能正常左心舒张功能欠佳。
3)骨髓活检:
骨髓活检示6-7个髓腔,造血细胞约占40%左右,巨核细胞可见,各系造血细胞未见明显异常,请结合临床。
4)皮肤活检:
病理检查:表皮未见明显异常,淋巴、组织细胞浸润呈栅栏样排列伴胶原渐进性坏死,可见少数多核组织巨细胞,结合临床可符合环状肉芽肿。


泛发性环状肉芽肿generalized granuloma annulare
二
诊断要点及鉴别诊断
01
诊断要点:
a.临床特点:
GA有多种临床表现,分为局限型、泛发性、皮下型、穿通型、斑片型、其他亚型(丘疹性脐形GA、线型GA、急性疼痛性肢端GA)
(1)局限型:红色或肤色、环形或弧形斑块,其边缘呈绳索样、硬度中等,伴中央消退。

图:红斑、非鳞屑、环状斑块
(2)泛发型:广泛分布的红色或肤色丘疹和斑块,直径从几毫米到几厘米不等。

图:播散性环状肉芽肿患者,手臂、腿部和躯干上出现了 200 多个直径从 5 到 25 毫米不等的环形病灶。
(3)皮下型:皮下型GA的特征为头皮或四肢出现单发或多发的真皮深部或皮下无痛性结节。结节表面的皮肤看起来正常。皮下型GA的皮损通常小于4cm,最常见于儿童小腿前部、手、头部和臀部。

图:多个无触痛的皮下结节。
(4)穿通型:穿通型GA的特点是真皮层受损的胶原排出到皮肤表面,最常见于儿童和年轻成人,表现为无症状的红色或肤色丘疹,可进展为分泌清亮或白色液体的脐形丘疹。一些皮损可类似于脓疱。穿通型GA可为局限性(通常位于四肢)或泛发性。少数患者存在瘙痒或疼痛,皮损愈合后留有瘢痕。
(5)斑片型:斑片型GA表现为无鳞屑的环形或非环形斑片。斑片可为局限性或泛发性,通常累及肢体近端。

图:腿部见红斑、无鳞屑性斑块。
b. 实验室检查:
(1)真菌直接镜检排除体癣。
(2)GA与血脂异常、糖尿病、HIV感染和恶性肿瘤可能相关:血脂全套检查、糖尿病相关检测、HIV、适龄的癌症筛查。
c. 组织病理学:
GA的特征性组织病理学表现为淋巴组织细胞浸润、胶原变性和黏蛋白沉积,这些表现通常呈栅栏样或间质模式。可通过阿尔新蓝突出显示黏蛋白沉积。局限型和泛发型GA均可见栅栏样和间质模式,斑片型GA通常为间质模式。
间质模式:特征为真皮中上层组织细胞嵌入嗜碱性黏蛋白并浸润于胶原束间。胶原纤维出现不完全变性。

图:左下部和左上部区域的 2 个不完全胶原变性区域,中间有大面积的正常真皮胶原(间质或不完全环状肉芽肿)。(HE染色 100x)
栅栏样模式:特征为真皮中上层淋巴组织细胞炎性浸润,而炎性浸润呈栅栏样包绕胶原及弹性蛋白变性区域。胶原变性区域表现为嗜酸性纤维物质被嗜碱性黏蛋白沉积物所分隔。也可能存在嗜酸性粒细胞。

图:大面积的坏死。该区域被组织细胞和淋巴细胞的外围边缘以及一些多核巨细胞包围。真皮的相邻区域显示正常的胶原束和成纤维细胞核 (HE 40x).

图:右侧为坏死中心,边缘见淋巴细胞和组织细胞,左侧为多核巨细胞(HE 400x).
图:上部坏死区显示微弱的嗜碱性粒细胞,代表细胞、纤维、嗜酸性粒细胞物质束间的粘液变性。边缘见组织细胞和一些淋巴细胞,伴有正常胶原的完全粘液变性 (HE 400x).
皮下型GA:常表现为在皮下组织内的结缔组织分隔中,大量的组织细胞呈栅栏样包绕变性的胶原和黏蛋白。
穿通型GA:表现为栅栏样淋巴组织细胞肉芽肿包绕的黏液样变性胶原纤维经表皮排出。

图:坏死肉芽肿位于真皮上部,在右侧可以看到无细胞物质刺穿表皮(HE 100x).
02
鉴别诊断:
a. 环形皮损的鉴别诊断:
1)体癣:体癣通常表现为环形斑块,周围可见鳞屑。而GA无鳞屑,这是临床检查时区分GA与体癣的关键特征。可采用KOH涂片或真菌培养来确认癣菌感染。
2)环状扁平苔癣:扁平苔癣环状皮损周边可见特征性的多边形紫罗兰色瘙痒丘疹,有助于与GA相鉴别。圆形、红色无瘙痒丘疹更符合GA。环状扁平苔癣常累及阴茎和阴囊。
3)皮肤结节病:结节病可表现为广泛分布的肤色丘疹和环形斑块。组织病理学检查发现裸露肉芽肿可将结节病与GA区分开。
4)环状弹性纤维溶解性巨细胞肉芽肿(光化性肉芽肿):环状弹性纤维溶解性巨细胞肉芽肿(annular elastolytic giant cell granuloma, AEGCG)表现为日晒处的皮肤出现环形红斑,活检可见真皮层中巨细胞吞噬弹力纤维;可能存在渐进性坏死和栅栏样肉芽肿。真皮层弹力纤维丢失和断裂以及不存在黏蛋白是鉴别该病与GA的特征性组织病理学表现。
5)离心性环状红斑:浅表或深部离心性环状红斑(erythema annulare centrifugum, EAC)通常表现为多个环形红色斑块。浅表EAC可见沿皮损内缘分布的特征性鳞屑,称为“跟随型鳞屑(trailing scale)”,而GA没有这种表现。不过,深部EAC常无鳞屑。根据组织病理学表现可将该病与GA区分开,EAC患者血管周围存在独特的密集淋巴细胞浸润。
6)间质性肉芽肿性皮炎:IGD与自身免疫性疾病、恶性肿瘤和药物有关。该病常表现为环形红色斑块,好发于躯干外侧和皮肤褶皱处。与GA相似,胶原变性和栅栏样组织细胞是IGD的组织病理学特征。存在中性粒细胞和不存在黏蛋白有助于将该病与GA区分开。
b. 泛发型丘疹性GA鉴别诊断:
1)二期梅毒: 典型的皮疹为弥漫性对称斑疹或丘疹,累及整个躯干和四肢,包括手掌和足底。单个皮损呈紫铜色、红色或红棕色,不连续,直径0.5-2cm。虽然皮损通常为鳞状,但也可能平滑。此外,也可能见到结节状病变。皮疹偶可伴瘙痒。
2)发疹性黄瘤: 发疹性黄瘤是1-5mm的红色至黄色丘疹,成片骤然出现。最常受累的部位是四肢伸面和臀部。可出现Koebner现象(皮肤创伤部位发疹性黄瘤的表现)。发疹性黄瘤高度提示高甘油三酯血症,血清甘油三酯水平常常超过1500-2000mg/dL。组织病理学:发疹性黄瘤表现为泡沫细胞、混合性炎性细胞浸润(包括淋巴细胞、中性粒细胞和组织细胞),以及胞外脂质沉积。在早期发疹性黄瘤中,泡沫细胞的数量可能很少。
3)发疹性汗管瘤:汗管瘤是小汗腺或顶泌汗腺的小肿瘤,表现为分散的多发性肤色丘疹,直径为2-4mm。这类肿瘤最常见于眶周区域。发疹性汗管瘤在儿童期或成年早期发病,累及颈前区、胸部、肩部、腹部和生殖器区域。汗管瘤的组织学表现为真皮浅层内双层立方形细胞围绕中央导管,上皮细胞呈多发性小区域聚集。在上皮聚集区域的一侧存在逐渐变窄的逗点样边缘。
三
治疗
环状肉芽肿已证明与自身免疫性疾病、糖尿病和高脂血症、恶性肿瘤等显著相关。最近的研究表明 T 辅助细胞1(Th1) 轴和JAK-STAT通路失调,某些感染触发因素也与 GA 相关。也有医源性 GA 的报道,尽管这些药疹的确切机制尚未阐明。最近的文献提出一种 GA的治疗阶梯。
局部使用和病灶内注射糖皮质激素是第一级治疗。如果局部和病灶内糖皮质激素治疗失败,氨苯砜、羟氯喹、甲氨蝶呤、己酮可可碱和柳氮磺胺吡啶可被视为第二级治疗。羟氯喹是首选的一线全身性治疗药物,该药通常耐受良好,需要对患者进行视网膜毒性监测,羟氯喹的成人常规剂量为一日3-5mg/kg(以实际体重计)。使用剂量通常为400mg/d,但为了尽量降低治疗相关眼毒性风险,不应超过5mg/(kg·d)。通常在1-2个月内症状明显改善。
泛发型GA的初始治疗通常采用全身性治疗,仅在治疗最麻烦或难治性皮损时联合外用疗法。如果 GA 对治疗仍然顽固,则可以考虑光疗和靶向免疫调节剂,例如阿普司特和托法替布,或生物疗法(阿达木单抗、度普利尤单抗、依那西普和英夫利昔单抗等)。
对于泛发性GA尤其是老年人,要警惕是否合并有恶性肿瘤的可能,特别是潜在的造血系统肿瘤和腺癌,肿瘤抗原诱发免疫反应,可导致肉芽肿性改变,因此,这类患者需进行全面检查。
文 | 王艺静
审 | 马英
编 | BEST
原标题:《医声医识 | 皮肤科医生的相面术》

